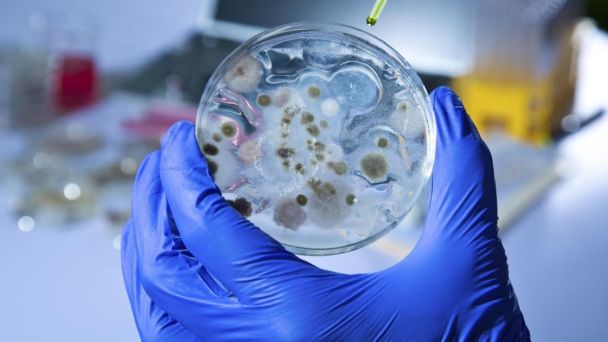

Luego de que fueron detectados más de mil 100 casos sospechosos de ántrax en solo cinco países de África, que han dejado al menos 20 muertes en lo que va del año, la Organización. Mundial de la Salud (OMNS) manifestó su temor por un brote incontrolable de este mal viral.
Aunque de acuerdo a la OMS por el momento solo se han notificado “casos esporádicos”, se teme que las muertes por este mal empiecen a aumentar ya que “los pacientes se presencian tarde en los centros de salud”, indicó el organismo.
Te Puede Interesar: VIDEO: Partido de futbol en CDMX termina en tiroteo con 2 muertos y 7 heridos
“De los cinco países, Zambia está presenciando su peor brote desde 2011, con nueve de sus diez provincias afectadas. Hasta el pasado 20 de noviembre el país había informado de 684 casos sospechosos, 25 confirmados y cuatro muertes”.
La OMS señaló desde Zambia en un comunicado que “De los cinco países, Zambia está presenciando su peor brote desde 2011, con nueve de sus diez provincias afectadas. Hasta el pasado 20 de noviembre el país había informado de 684 casos sospechosos, 25 confirmados y cuatro muertes”.
Sin embargo, también han aparecido brotes en Kenia, Malaui, Uganda y Zimbabue, donde de por sí el ántrax es una enfermedad endémica y surgen brotes estacionales todos los años.
Además, esta institución de la ONU advirtió la posibilidad de que la enfermedad empiece a transmitirse desde Zambia a otros países “debido a los frecuentes movimientos transfronterizos de animales y humanos”, elevando “el riesgo de una propagación regional”.
Matshidiso Moeti, directora para África de la OMS, recalcó en el comunicado “Para terminar con estos brotes debemos romper el ciclo de infección previniendo primero la enfermedad en los animales. Estamos apoyando los esfuerzos de los países de control de los brotes”.
El ántrax (o canbunco) es una enfermedad bacteriana infecciosa grave que afecta a los herbívoros domésticos y salvajes. Puede transmitirse a los humanos con el contacto con animales infectados o por la exposición de productos de esos animales contaminados.
Brote de ántrax en África enciende las alarmas de la OMS
Con Información de Agencias